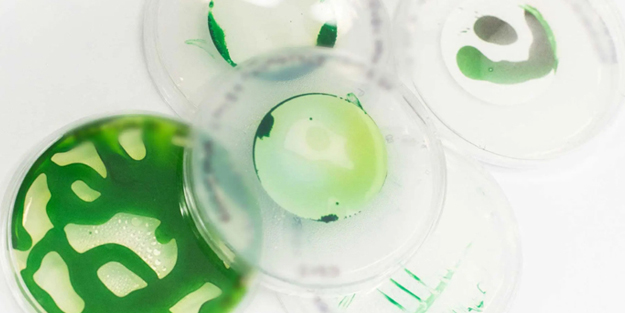
Petrol yiyen mikroplar dünyanın en 'ucuz' ve en 'temiz' hidrojenini salgılayacak! Petrol yiyen bakteri çığır açacak

Galatasaray'ın sezon başında Napoli'den sezon başında kadrosuna kattığı ve transferiyle büyük ses getiren 35 yaşındaki Belçikalı oyuncu Dries Mertens ile alakalı yeni gelişmeler yaşanıyor. Şu ana kadar gösterdiği performansla henüz beklentileri karşılayamayan yıldız isim için çok konuşulacak bir iddia ortaya atıldı.
Galatasaray'ın sezon başında Napoli'den sezon başında kadrosuna kattığı ve transferiyle büyük ses getiren 35 yaşındaki Belçikalı oyuncu Dries Mertens ile alakalı yeni gelişmeler yaşanıyor. Şu ana kadar gösterdiği performansla henüz beklentileri karşılayamayan yıldız isim için çok konuşulacak bir iddia ortaya atıldı.
Yeni sezonda mutlak şampiyonluk hedefleyen Galatasaray, sezon öncesi yaptığı transferlerle adından en çok söz edilen takımlardan biri olmuştu. Sarı-Kırmızılılar kadrosunu Abdülkerim Bardakcı, Kazımcan Karataş, Sergio Oliviera, Leo Dubois, Seferovic, Fredrik Midtsjö, Torreira, Mertens, Icardi, Milot Rashica, Juan Mata, Yusuf Demir, Mathias Ross Jensen isimleriyle güçlendirirken, büyük umutlarla transfer edilen bazı isimlerle alakalı olarak yeni gelişmeler yaşanıyor.
Sarı-Kırmızılılar'ın sezon başında Paris Saint-Germain'den kiralık olarak kadrosuna kattığı Mauro Icardi ile ilgili çarpıcı bir iddia gündeme gelmişti. Arjantin'de yayın yapan radyo kanalı RedBoing'in iddiasına göre Mauro Icardi, kendisi adına radikal bir karar almayı düşündüğü, bu kapsamda futbolu bırakma ihtimalini düşündüğü öne sürülmüştü.
Icardi'den gelen bu haberle şok yaşayan Galatasaray cephesinde bir çarpıcı gelişme daha yaşandı. Buna göre; Yaz transfer döneminde büyük umutlarla Galatasaray’a gelen ama hayal kırıklığı yaratan bir başlangıç yapan Dries Mertens'in de ayrılması gündemde... Her fırsatta soluğu eski şehri Napoli’de alan ve fahri hemşerilik unvanı aldığı İtalyan kentinden kopamıyor. Belçikalı oyuncu ''bay'' haftasında da eşi Kate ve oğlu Ciro ile Napoli’nin yolunu tuttu ve boşaltmadıkları evlerinde kaldı.
SEZON SONU VEDA
Ortaya atılan iddiaya göre; Mertens'in planı ise bu sezon beklediği gibi bir sezon geçiremezse yeşil sahalara veda etmek. Daha sonra Napoli’de kendisine verilecek bir göreve hazırlanmak. Napolili yöneticilerle dahi bu konuda görüşmeler gerçekleştirdi. Dries Mertens’in Galatasaray’la 1+1 yıllık sözleşmesi bulunuyor.
Dries Mertens, Napoli'de 9 yıl futbol oynadı. 2013 yılında PSV Eindhoven'dan 9.5 milyon Euro'ya Napoli'ye transfer olan Belçikalı oyuncu, İtalyan kulübünde unutulmazlar arasına girmeyi başardı.